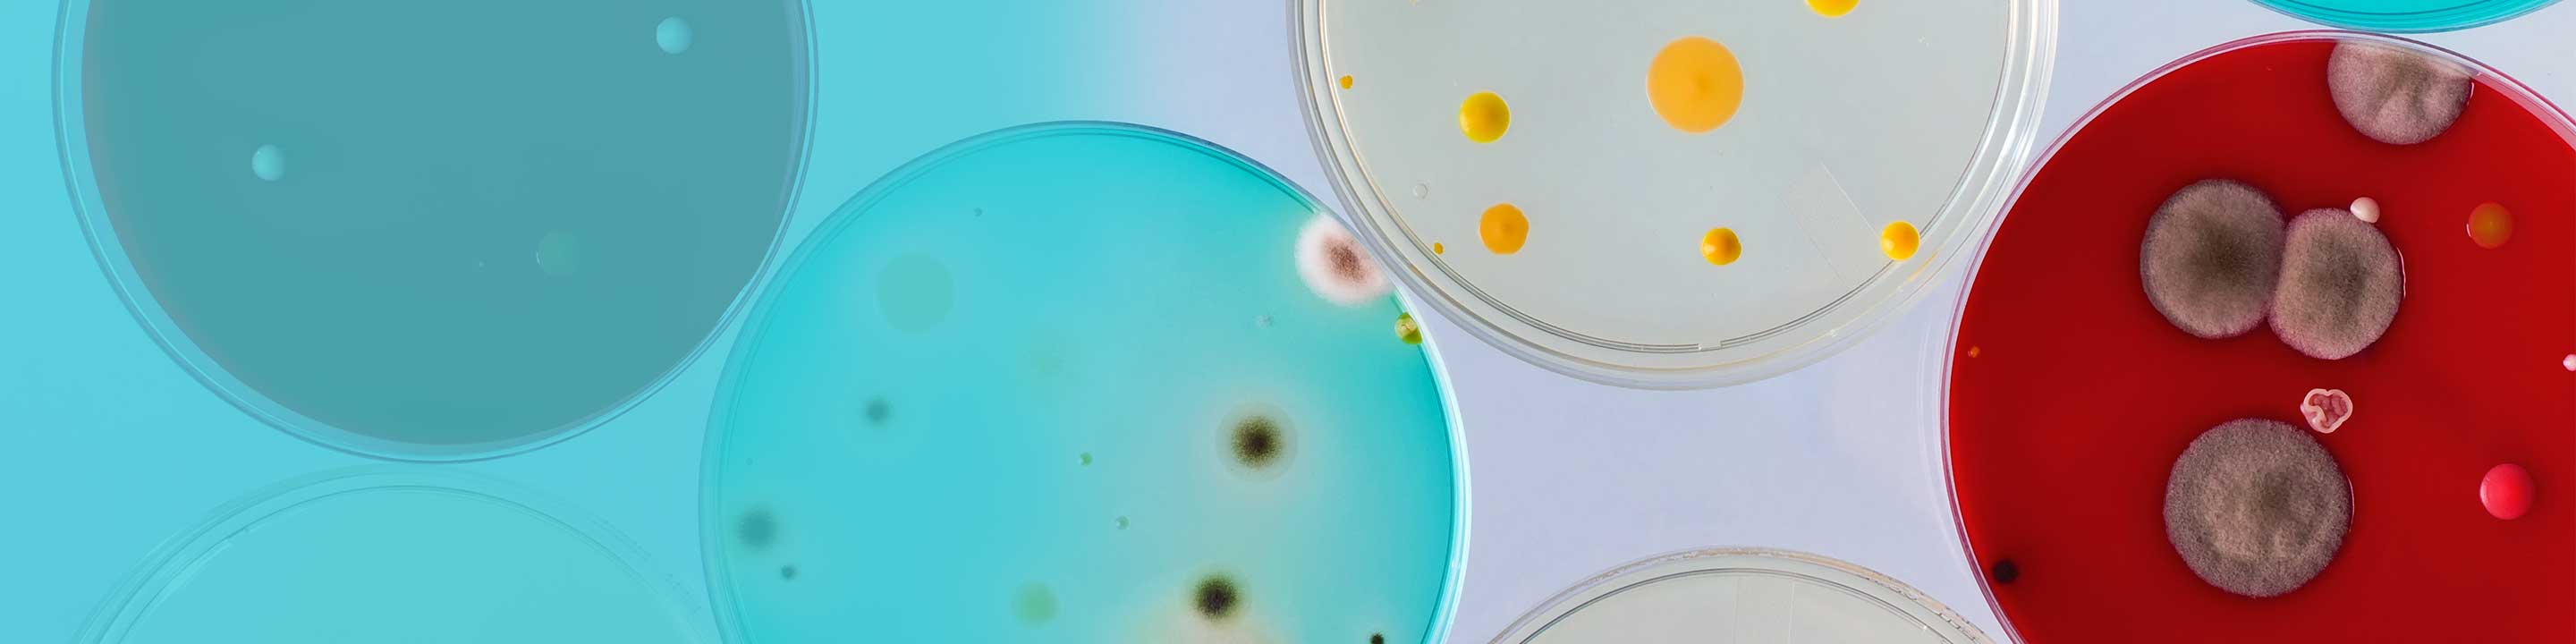

-
Reagents
- Flow Cytometry Reagents
-
Western Blotting and Molecular Reagents
- Immunoassay Reagents
-
Single-Cell Multiomics Reagents
- BD OMICS-Guard™ Sample Preservation Buffer
- BD® AbSeq Assay
- BD® Single-Cell Multiplexing Kit
- BD Rhapsody™ ATAC-Seq Assays
- BD Rhapsody™ Whole Transcriptome Analysis (WTA) Amplification Kit
- BD Rhapsody™ TCR/BCR Next Multiomic Assays
- BD Rhapsody™ Targeted mRNA Kits
- BD Rhapsody™ Accessory Kits
- BD® OMICS-One Protein Panels
- BD OMICS-One™ WTA Next Assay
- BD OMICS-Guard™ CRYO Preservation Buffer
-
Functional Assays
-
Microscopy and Imaging Reagents
-
Cell Preparation and Separation Reagents
-
Dehydrated Culture Media
Old Browser
Looks like you're visiting us from {countryName}.
Would you like to stay on the current country site or be switched to your country?
Dehydrated Culture Media
BD offers several media solutions for microbial and molecular genetics applications. From animal- based culture media to animal-free protein sources and various formulations specifically suited for molecular genetics and agars, we provide an array of culture media options for your research. Explore our offerings below:
Animal-based culture media and ingredients
Our animal-based culture media and ingredients are used in microbiological and cell cultures as nutritional supplements for microorganisms. All animal tissues used are sourced in a controlled and validated way as to reduce risk of contamination or exposure to any diseases, especially Bovine Spongiform Encephalopathy (BSE).
To view the list of products and order

Molecular genetics media formulations
BD Molecular genetics media formulations are specifically designed for growing cell cultures for molecular genetic studies. They are made to be especially rich and nutritious in order to offer excellent growth support for the fastidious organisms used in molecular genetic studies.

Select Alternative Protein Source (APS) media
Animal-free APS™ (Alternative Protein Source) bacteriological media are specifically formulated for growing cell cultures for bacteriological and molecular genetics studies, utilizing animal-free ingredients.

Agars
BD manufactures several different types of agars that are suitable for different applications.
